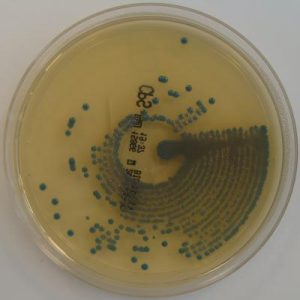

Psenicne Mekinje
 Psenicne Mekinje Za Lecenje Raka Debelog Creva U Jednoj Poznatoj
Psenicne Mekinje Za Lecenje Raka Debelog Creva U Jednoj Poznatoj

 Kako Se Koriste Psenicne Mekinje Kao Lek Lecenje Biljem Food Salt
Kako Se Koriste Psenicne Mekinje Kao Lek Lecenje Biljem Food Salt
 Psenicne Mekinje Lek Od Glave Do Pete Ciste Creva I Krv Od Masnoca
Psenicne Mekinje Lek Od Glave Do Pete Ciste Creva I Krv Od Masnoca
 Psenicne Mekinje 250 Gr Biofor
Psenicne Mekinje 250 Gr Biofor
 17 Best Food Grains Images Delhi Indien Getreide Gelb
17 Best Food Grains Images Delhi Indien Getreide Gelb
Zitarice Mahunarke Musli Keksi Psenicne Mekinje
 Psenicne Mekinje Pakovane Nutricia Mesto Zdrave Hrane
Psenicne Mekinje Pakovane Nutricia Mesto Zdrave Hrane
 Ovsene Zobene I Psenicne Mekinje Kalorije Prednosti I Recepti
Ovsene Zobene I Psenicne Mekinje Kalorije Prednosti I Recepti
 Psenicne Mekinje Za Bolju Probavu
Psenicne Mekinje Za Bolju Probavu
 Psenicne Mekinje Lekovita Svojstva I Priprema
Psenicne Mekinje Lekovita Svojstva I Priprema
 Psenicne Mekinje I Klice Lekovita Svojstva Dijeta I Zdravlje
Psenicne Mekinje I Klice Lekovita Svojstva Dijeta I Zdravlje
Cereals Pulses Vega Beyond Health Food
 Schneekoppe Psenicne Mekinje 200 G Konzum Klik
Schneekoppe Psenicne Mekinje 200 G Konzum Klik
 Psenicne Mekinje Lekovitost I Recept
Psenicne Mekinje Lekovitost I Recept
 Psenicne Mekinje Lek Za Zeludac Mekinje Kao Hrana I Lek
Psenicne Mekinje Lek Za Zeludac Mekinje Kao Hrana I Lek
 Encian Up Bran Packed In 250 G
Encian Up Bran Packed In 250 G
 Mekinje Zdravlje Je U Omotacu Nadijeti Com
Mekinje Zdravlje Je U Omotacu Nadijeti Com
 Psenicne Mekinje Dobra Hrana Za Zdravlje I Recepti
Psenicne Mekinje Dobra Hrana Za Zdravlje I Recepti

 Psenicne Mekinje Moja Slatka Kuhinja
Psenicne Mekinje Moja Slatka Kuhinja
Mekinje Su Najbolje Za Probavu
 Najukusniji Dukan Kruh Recipe Lchf Paleo Raw Gluten Free Dukan
Najukusniji Dukan Kruh Recipe Lchf Paleo Raw Gluten Free Dukan
Organico Prodavnica Organske Psenicne Mekinje 500g
 Ovsene Zobene I Psenicne Mekinje Kalorije Prednosti I Recepti
Ovsene Zobene I Psenicne Mekinje Kalorije Prednosti I Recepti
 Nase Dobro Organske Psenicne Mekinje Hiper
Nase Dobro Organske Psenicne Mekinje Hiper
 Index Of Wp Content Uploads 2016 02
Index Of Wp Content Uploads 2016 02
 Psenicne Posije Cuvaju Zdravlje I Ubrzavaju Probavu Fitness Com Hr
Psenicne Posije Cuvaju Zdravlje I Ubrzavaju Probavu Fitness Com Hr
 Psenicne Mekinje Organske Sa Klicama Nase Dobro
Psenicne Mekinje Organske Sa Klicama Nase Dobro
 Index Of Wp Content Uploads 2015 12
Index Of Wp Content Uploads 2015 12
 Organske Psenicne Mekinje Klice Piazza Organica Prodavnica
Organske Psenicne Mekinje Klice Piazza Organica Prodavnica
 Rice Long Grain Brown Grains Rice Plantbased Plantbasedlink
Rice Long Grain Brown Grains Rice Plantbased Plantbasedlink
 Encian Up Bran Packed In 250 G
Encian Up Bran Packed In 250 G
 Psenicne Mekinje Gamus Tuzla Proizvodnja I Pakovanje
Psenicne Mekinje Gamus Tuzla Proizvodnja I Pakovanje
 Pecivo Integralne Psenicne Mekinje 60g Idea Pekara Idea
Pecivo Integralne Psenicne Mekinje 60g Idea Pekara Idea
 Psenicne Mekinje Fiber Up Najave Sensa Hr
Psenicne Mekinje Fiber Up Najave Sensa Hr
 Psenicne Mekinje Interpak 250g
Psenicne Mekinje Interpak 250g
 Psenicne Mekinje Lekovita Svojstva I Priprema
Psenicne Mekinje Lekovita Svojstva I Priprema
 Psenicne Mekinje Tagovi Coolinarika
Psenicne Mekinje Tagovi Coolinarika
Novi Proizvod Na Trzistu Fiber Up Psenicne Mekinje Ordinacija Hr
 Susene Psenicne Mekinje Zdrava Hrana
Susene Psenicne Mekinje Zdrava Hrana
 Psenicne Pahuljice 400 Gr Biofor
Psenicne Pahuljice 400 Gr Biofor
 Caj Od Djumbira Recept Djumbir I Med Za Zdravlje
Caj Od Djumbira Recept Djumbir I Med Za Zdravlje
 Najukusniji Dukan Kruh Recipe Dukan Dijeta Recepti Banana
Najukusniji Dukan Kruh Recipe Dukan Dijeta Recepti Banana
 Psenicne Mekinje Njihov Sastav Koristi I Stete Za Tijelo Dijete
Psenicne Mekinje Njihov Sastav Koristi I Stete Za Tijelo Dijete
 Fiber Up Psenicne Posije 250 G Encian Konzum Klik
Fiber Up Psenicne Posije 250 G Encian Konzum Klik
 Ovsene Mekinje Bio Zrnce Novi Sad Kuca Zdrave Hrane
Ovsene Mekinje Bio Zrnce Novi Sad Kuca Zdrave Hrane
 Mekinje Psenicne Dll 150g Brasno Dooobra Hrana Zdrava I
Mekinje Psenicne Dll 150g Brasno Dooobra Hrana Zdrava I
 Koje Su Prednosti I Stete Psenicne Mekinje
Koje Su Prednosti I Stete Psenicne Mekinje
Sildenafil Generic Pfizer Viagra
 Nada Nemcic Nadanemcic Instagram Photos Piknu
Nada Nemcic Nadanemcic Instagram Photos Piknu
 Psenicne Mekinje Kasa Za Obloge Prirodar
Psenicne Mekinje Kasa Za Obloge Prirodar
 Encian Fiber Up Psenicne Mekinje 250 Gr Bio Kutak Ekupi Ba
Encian Fiber Up Psenicne Mekinje 250 Gr Bio Kutak Ekupi Ba
 Free Online Website Malware Scanner Website Security Monitoring
Free Online Website Malware Scanner Website Security Monitoring
 Psenicne Mekinje Za Mrsavljenje Recepti Kako Se Poduzeti
Psenicne Mekinje Za Mrsavljenje Recepti Kako Se Poduzeti
 Ovsene Mekinje Treba Da Budu Deo Svakodnevne Ishrane Saznajte Zasto
Ovsene Mekinje Treba Da Budu Deo Svakodnevne Ishrane Saznajte Zasto
 Psenicne Mekinje Tagovi Coolinarika
Psenicne Mekinje Tagovi Coolinarika
 Kako Estrogen Utjece Na Zenske Obline I Kako Ga Prirodno Regulisati
Kako Estrogen Utjece Na Zenske Obline I Kako Ga Prirodno Regulisati
 Zelena Recenzija Psenicne Mekinje Misszdrava
Zelena Recenzija Psenicne Mekinje Misszdrava
Psenicne Mekinje Za Mrsavljenje I Bolju Probavu Saznaj Lako
 Mekinje Psenicne Vega 250 G Suvo Voce Povrce Bilje Dooobra
Mekinje Psenicne Vega 250 G Suvo Voce Povrce Bilje Dooobra
 Psenicne Mekinje Tagovi Coolinarika
Psenicne Mekinje Tagovi Coolinarika
 30 Best D R Foods Ltd Images Meal White Rice Whole Wheat Flour
30 Best D R Foods Ltd Images Meal White Rice Whole Wheat Flour
Index Of Wp Content Uploads 2015 06
Index Of Wp Content Uploads 2015 06
Psenicne Mekinje A Zitopromet Bijeljina
 Mekinje Klice Pahuljice Coolinarika
Mekinje Klice Pahuljice Coolinarika
 Schneekoppe Psenicne Mekinje 200 G Konzum Klik
Schneekoppe Psenicne Mekinje 200 G Konzum Klik
 Organske Psenicne Mekinje Sa Medom 200g Profexd
Organske Psenicne Mekinje Sa Medom 200g Profexd
Psenicne Posije Cuvaju Zdravlje I Ubrzavaju Probavu Fitness Com Hr

 Schneekoppe Psenicne Mekinje 200g Zitarice I Mahunarke Ekupi Ba
Schneekoppe Psenicne Mekinje 200g Zitarice I Mahunarke Ekupi Ba
Psenicne Mekinje 30 1 Mlin I Pekara Ljubace D D
Psenicne Mekinje 30 1 Mlin I Pekara Ljubace D D
 Mekinje Izvor Zdravlja I Dobrog Izgleda Magicno Bilje
Mekinje Izvor Zdravlja I Dobrog Izgleda Magicno Bilje
 Organske Mekinje Psenicne 400g Piazza Organica Prodavnica
Organske Mekinje Psenicne 400g Piazza Organica Prodavnica
 Caj Od Persuna Lekovita Svojstva Caja Od Persuna
Caj Od Persuna Lekovita Svojstva Caja Od Persuna
 Psenicne Mekinje Za Bolju Probavu
Psenicne Mekinje Za Bolju Probavu
 Koje Su Prednosti I Stete Psenicne Mekinje
Koje Su Prednosti I Stete Psenicne Mekinje
 Zitarice Gamus Tuzla Proizvodnja I Pakovanje Prehrambenih
Zitarice Gamus Tuzla Proizvodnja I Pakovanje Prehrambenih
Gorusica Bol U Predelu Grudne Kosti Zeluca I Kako Spreciti Gorusicu
Kikindski Mlin Ad Sterilizovane Psenicne Mekinje Za Ljudsku Ishranu












Comments
Post a Comment